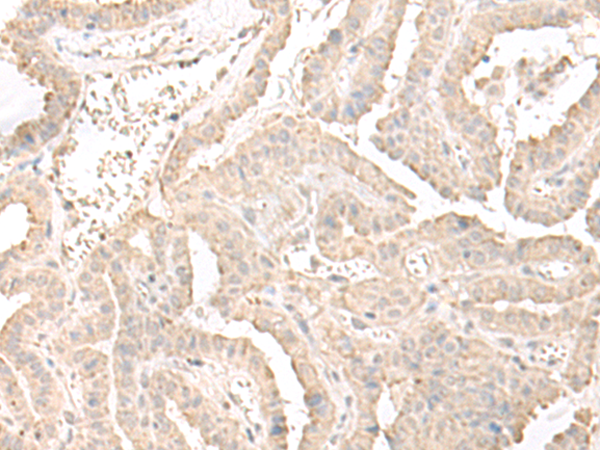

中文名稱: 兔抗ERGIC3多克隆抗體
|
Background: |
Possible role in transport between endoplasmic reticulum and Golgi. |
|
Applications: |
ELISA, WB, IHC |
|
Name of antibody: |
ERGIC3 |
|
Immunogen: |
Fusion protein of human ERGIC3 |
|
Full name: |
ERGIC and golgi 3 |
|
Synonyms: |
Erv46; CGI-54; C2orf47; PRO0989; C20orf47; NY-BR-84; SDBCAG84; dJ477O4.2 |
|
SwissProt: |
Q9Y282 |
|
ELISA Recommended dilution: |
5000-10000 |
|
IHC positive control: |
Human thyroid cancer |
|
IHC Recommend dilution: |
50-300 |
|
WB Predicted band size: |
43 kDa |
|
WB Positive control: |
K562 cell lysate |
|
WB Recommended dilution: |
500-2000 |

購物車
購物車 幫助
幫助
 021-54845833/15800441009
021-54845833/15800441009
